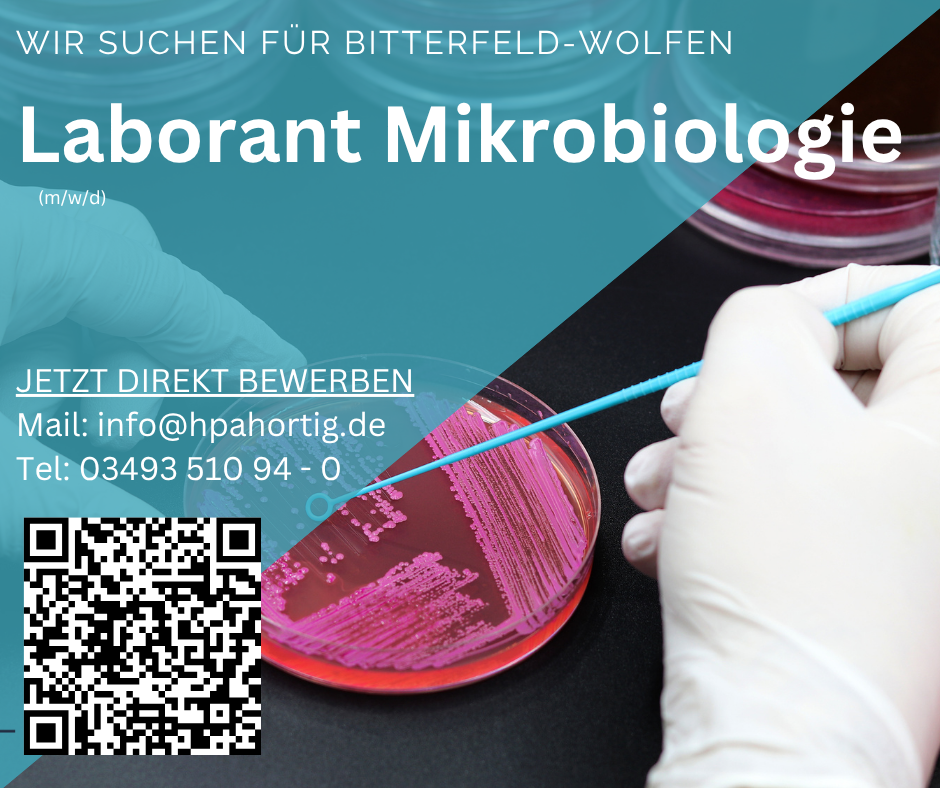

Laborant (m/w/d) Mikrobiologie - Bitterfeld - Tagschicht / Gleitzeit - ab 3.200 €
Für unser Auftraggeber aus der Region Bitterfeld-Wolfen suchen wir einen Laboranten (m/w/d) für die Mikrobiologie in einer reinen Tagschicht mit Gleitzeit.
Voraussetzungen:
- abgeschlossene Berufsausbildung als Laboranten / CTA / PTA / MTA / Mikrobiologin (m/w/d)
- Berufserfahrungen in der Mikrobiologie vom Vorteil
- Methodenkenntnisse in der Mikrobiologie
- Kenntnisse im GMP Bereich wünschenswert
- Computerkenntnisse erforderlich
Ihre Aufgaben:
- Überwachung und -prüfung
- Durchführung von mikrobiologisches Umgebungsmonitoring
- Keimzahlbestimmung
- Endotoxin-Analytik
- Umgang mit Labor- und Messgeräte
- Wartung, Pflege und Kalibrierung der Gerätschaften
- Dokumentation im EDV-System (LIMS)
Modalitäten:
- Arbeitsort: Bitterfeld-Wolfen
- Arbeitszeit: Vollzeit (Tagschicht Mo-Fr - in Gleitzeit)
- Entgelt: ab 3.200 € - je nach Qualifikation
- Sonderleistungen: Urlaubs- und Weihnachtsgeld, VWL, Betriebsrente, Jobrad
Wenn eines unserer Stellenangebote Ihr Interesse geweckt hat, schicken Sie uns Ihre Bewerbungsunterlagen an folgende Anschrift:
HPA Hortig Personal- und Arbeitsvermittlung
Hallesche Straße 28, OT Bitterfeld
06749 Bitterfeld-Wolfen
Kontakt: Nicky Hortig
Telefon: 03493 51094-0
Telefax: 03493 51094-10
Mail:Diese E-Mail-Adresse ist vor Spambots geschützt! Zur Anzeige muss JavaScript eingeschaltet sein.
WhatsApp: 03493510940
Hallesche Straße 28, OT Bitterfeld
06749 Bitterfeld-Wolfen
Kontakt: Nicky Hortig
Telefon: 03493 51094-0
Telefax: 03493 51094-10
Mail:
WhatsApp: 03493510940
HPA Hortig Personal- und Arbeitsvermittlung
Hallesche Straße 28, OT Bitterfeld
06749 Bitterfeld-Wolfen
|
Kontakt:
Telefon:
Telefax:
E-Mail:
WhatsApp:
|
Nicky Hortig
03493 51094-0
03493 51094-10
03493 510940
|
